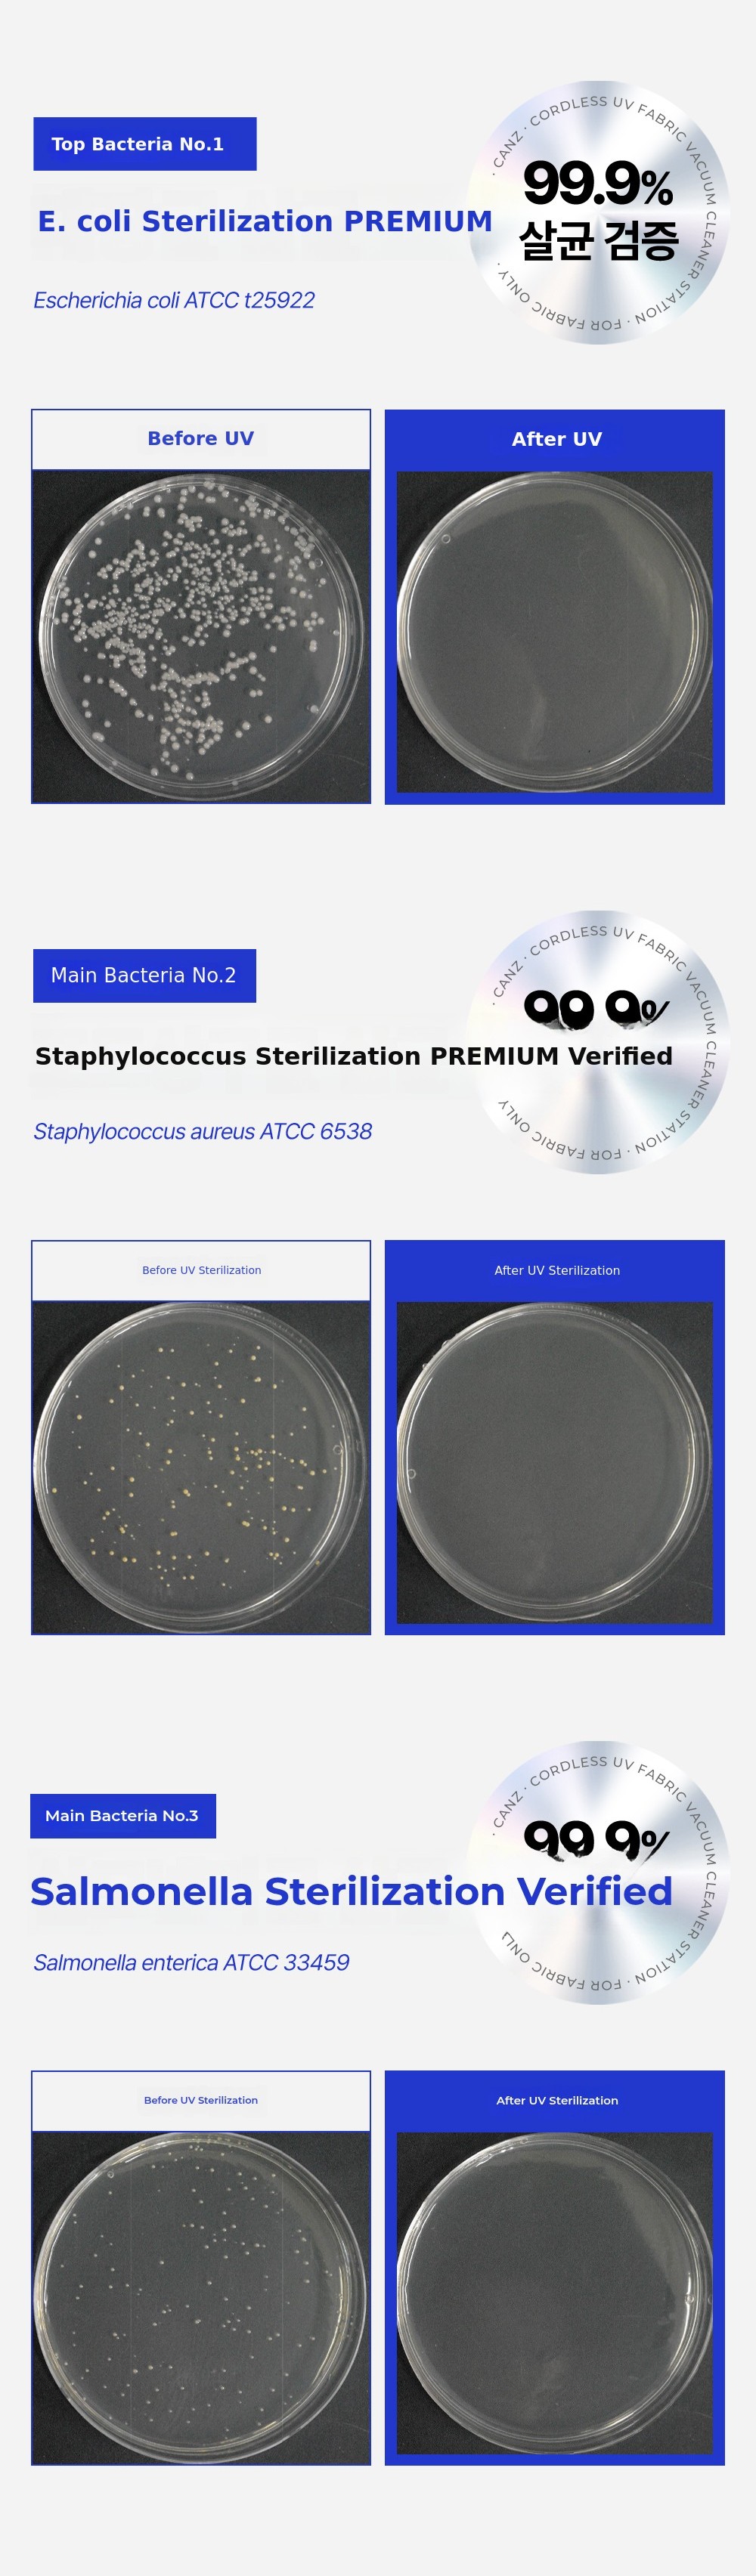

Shake it off and sterilize!
Shake it off and sterilize!

Sneezing and stuffy nose that repeat every time the season changes and every morning when you wake up.
I have lived with this discomfort for over 10 years already.
Of course, a regular vacuum cleaner couldn't solve it.
That experience was the starting point.
Based on the limitations I felt while using various bedding cleaners myself, I wanted to develop a product with a structure truly suited for bedding.
For three years, I kept improving it without stopping,
and the result, developed through hands-on use, is the automatic self-emptying bedding cleaner I am introducing now.
The feature I am especially proud of isautomatic filter cleaning.
The filter structure was modified dozens of times to prevent hair from tangling,
and although it was technically difficult to implement, we finally completed patent registration.
With just one product,automatic emptying, automatic filter cleaning, and dual UV sterilization are all included,
packing in every function needed for bedding cleaning.
Now, just lightly gliding it over your bedding every day will make freshness a part of your daily life.
No more touching dangerous bedding dust with your hands.
Simply push it comfortably, and your bedding will feel fresh like new every day.
We hope you try it yourself and start and end your day in a comfortable bed.
Thank you.
Why Wadiz?
Thanks to the trust and support of over 7,000 backers,
We have achieved cumulative sales of 2 billion won and gained extensive crowdfunding experience.
This bedding cleaner is a heartfelt result, embodying all that time and effort.
That is why we wanted to introduce the 'new world of bedding cleaning' first,and share it with you.
We will make your bed, where you lie every day, more pleasant.
Be the first to join us!

Shipping Method Courier (Maximum daily shipments: 500 orders)
Courier Company CJ Logistics
Shipping Fee 3,000 KRW (The shipping schedule may vary depending on the quantity of rewards, and any changes will be announced in advance through updates.)
Shipping Information for Islands and Mountainous Areas
For Jeju and other island or mountainous regions, please select the additional shipping fee for these areas.
Inquiries about products and delivery
-You can contact us via [Contact the Maker] or Inttech7@naver.com.
-Please note that the delivery company is closed on all public holidays and Sundays during the delivery break period.
-Customer Center 031-945-8695 / Consultation Mon-Fri 10:00~18:00
Payment methods For inquiries, Wadiz Customer Center 1661-9056
A/S Customer Center 031-945-8695 / Consultation hours Weekdays (Mon-Fri) 10:00~18:00
1. For 7 days after receiving the reward, the Wadiz refund policy applies to product defects.
2. In case of a refund due to product defects, all costs incurred will be borne by the maker.
3. Free A/S is not available if the product is damaged or lost due to the supporter’s intentional or negligent actions.
4. Returns are not possible if the product has been assembled or bolts have been used.
For paid warranty cases
Even during the warranty period, costs will be incurred in the following cases.
1. Damage caused by liquid penetration or foreign substance intake
2. Damage or malfunction caused by dropping or impact
3. Exterior damage caused by volatile solvents (e.g., thinner, benzene)
4. Malfunction caused by parts that are not genuine parts/consumables
5. Use of incorrect voltage
6. Loss or damage of parts due to unauthorized disassembly
7. Third-party repair or modification without official approval
8. Damage caused by natural disasters
9. Failure to follow safety instructions
10. Operation without filters or consumables installed
11. Improper use or lack of maintenance
Supporter Guide
- Reward options, shipping address, and card information can be modified on the My Wadiz > Funding > Funding History page until the end of the funding period.
- Funding End After Unavoidable Reason Shipping address Need to change Who Person Relevant Page My to the maker inquiry through Please make an inquiry.
 LNT tech Co.,LTD
LNT tech Co.,LTD

